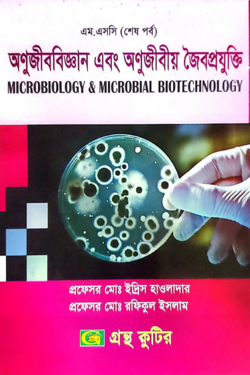
thumbnail

15

অণুজীববিজ্ঞান এবং অণুজীবীয় জৈবপ্রযুক্তি - মাস্টার্স ফাইনাল - কোড-৩১৩০০৯ - উদ্ভিদবিজ্ঞান বিভাগ
লেখক : প্রফেসর মোঃ ইদ্রিস হাওলাদার
প্রকাশনী : গ্রন্থ কুটির
বিষয় : উদ্ভিদবিজ্ঞান বিভাগ: মাস্টার্স
পৃষ্ঠা : 328, সংস্করণ : 1st published, 2022, ভাষা : বাংলা
২৯৩৳৩৪৫৳(১৫% ছাড়ে)
Wishlist
বন্ধুদের সাথে শেয়ার করুন
Share in social network
To reach the highest traffic view share this product
or copy link
অফারে আরো যা পাচ্ছেন
৩৯৯৯ ৳ অর্ডারে Wafilife Branded MUG ফ্রী! (২৮ মে - ২৯ মে)
সর্বনিম্ন কেনাকাটা:৩,৯৯৯ টাকা
মেয়াদ শেষ:২৯ মে, ২০২৬
৯৯৯ ৳ অর্ডারে আতর ফ্রি! (২২ মে - ৩১ মে)
সর্বনিম্ন কেনাকাটা:৯৯৯ টাকা
মেয়াদ শেষ:৩১ মে, ২০২৬
৪৯৯ ৳ অর্ডারে প্রিমিয়াম বুকমার্ক ফ্রী ! (২২ মে - ৩১ মে)
সর্বনিম্ন কেনাকাটা:৪৯৯ টাকা
মেয়াদ শেষ:৩১ মে, ২০২৬
রিভিউ এবং রেটিং
0.00
0 Ratings
0
0
0
0
0
Loading...



